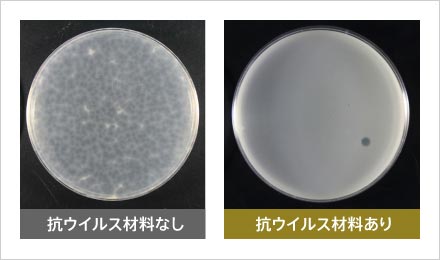
COVID19と同様のエンベロープ型ウイルスに対する抗ウイルス性能（6時間後）。ほぼすべてのプラークが消滅していることが分かる。
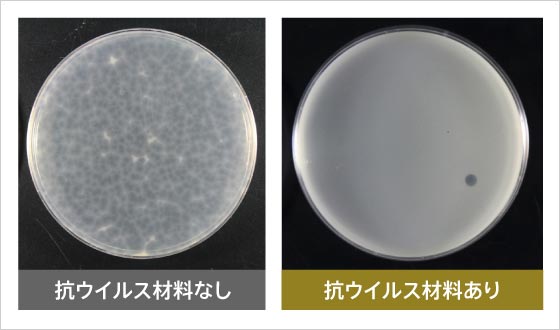
COVID19と同様のエンベロープ型ウイルスに対する抗ウイルス性能（6時間後）。ほぼすべてのプラークが消滅していることが分かる。

研究
研究


新型コロナウイルス感染症の世界的な広がりは、未だにとどまるところを知らず、猛威をふるっている。製薬会社や医学系の大学を中心にワクチンや治療薬の研究開発が精力的に進められている。RNAワクチン※のような新しい技術も試みられ、科学技術への期待感が増している。
東京工業大学は理工系総合大学として医工連携を推進しており、工学の立場から医療・公衆衛生への展開を見据えた研究も数多く行われている。感染症に関しても、抗ウイルス材料、抗体を用いた迅速で高感度なウイルス検出法、人体に貼り付ける血流測定法、電磁気を活用した血栓のできにくいECMO(エクモ:体外式膜型人工肺)、スーパーコンピュータTSUBAMEを用いたAI創薬など、新しいコンセプトの研究が盛んに行われている。
本特集では、これら5件の研究を紹介し医療・公衆衛生の未来を提示するとともに、それぞれの研究者から、今後の社会を担う若手研究者や学生へ向けたメッセージを届ける。
※RNAワクチン:従来のワクチンは不活化した病原体や病原体の一部のタンパク質を使うことで免疫反応を起こす。これに対し、RNAワクチン、DNAワクチンは遺伝子を投与することで、体内でタンパク質が作られ免疫反応を引き起こす。
物質理工学院 中島章 教授
元々環境浄化や省エネルギーに繋がる無機機能材料の研究を行っており、有害物質を浄化・除去する光触媒や、水との相互作用を抑制する撥水材料などの開発を目指していました。3年ほど前に、光触媒を研究する過程で、酸化モリブデン(MoO3)が優れた抗菌活性を示すことを知りました。MoO3は水に溶けやすく活性がすぐに失われてしまうのですが、撥水性の高い希土類のランタン(La)酸化物とMoO3との複合酸化物(La2Mo2O9、LMO)を作製したところ、撥水性だけでなく、非常に高い抗菌活性と抗ウイルス活性を同時に示すことがわかりました。LMOは、従来の無機系の抗菌・抗ウイルス材料である銀に比べて安価なうえ、酸化物なので腐食による経年劣化や着色がありません。光触媒として使われる酸化チタン(TiO2)と異なり光がなくても高い活性を示すなど、数多くの長所をもつことから、現在、神奈川県立産業技術総合研究所と共同で、実用化に向けた研究開発を進めています。

α-La2Mo2O9 の構造(新材料:LMO)
I. Evans, Chem. Mater., 17, 4074 (2005)


COVID19と同様のエンベロープ型ウイルスに対する抗ウイルス性能(6時間後)。
ほぼすべてのプラークが消滅していることが分かる。
LMOは当初ノロウイルスの代替ウイルスに対しては非常に高い抗ウイルス活性を示す一方、インフルエンザウイルスの代替ウイルスに対しては、それほど高い活性を示しませんでした。新型コロナウイルス(SARS-CoV-2)は、インフルエンザウイルスと同様のエンヴェロープ型ウイルスです。LMOの活性を高めるため、構成する元素の一部を他の元素に置き換える検討を行ったところ、昨年、インフルエンザ代替ウイルスに対しても、極めて高い抗ウイルス活性を示すLMOの開発に成功しました。 今回のCOVID-19を経験してわかったことは、ワクチンが開発され普及するまで、私たちはマスクの着用、ソーシャルディスタンスの確保といった新常態を高い意識レベルで取り入れ、経済活動や社会活動を止めずに持ちこたえなければならないということです。そのために「予防」や「感染抑制」の技術は、治療薬やワクチンの開発と同じくらい重要です。LMOのような抗ウイルス材料は、切り札の一つとなるでしょう。さらに、近年頻発している大規模自然災害等の被災地での衛生環境確保においても、この材料は有効になると考えています。

COVID19と同様のエンベロープ型ウイルスに対する抗ウイルス性能(6時間後)。ほぼすべてのプラークが消滅していることが分かる。
LMOの抗ウイルス活性の詳細なメカニズムは、実はまだよくわかっていません。撥水性が抗菌・抗ウイルス活性に対しても一定の効果があることが報告されています。そのため、今後、理論と実験の両面からメカニズムの解明を図っていく方針です。また、現在、20社以上の企業から問い合わせを受けていますが、これらの企業にサンプル材料を提供していく計画です。例えば、LMOを練りこんだコーティング材として、壁紙やスマートフォン、乗り物の吊り革などへの応用が考えられます。今後1年半~2年以内に企業の方々に製品化していただき、少しでも社会に貢献できるとうれしいです。
中島章教授からのメッセージ

中島 章
物質理工学院 材料系 教授
中島章教授からのメッセージ
今回、COVID-19の世界的な感染拡大により、私が2年前に開発したLMOが注目されるようになりました。しかし、元々私は人類を救おうとか実用化してお金儲けをしようといった動機で、LMOの研究を始めたわけではありません。単なる知的好奇心からでした。それが結果的に社会の役に立てるかも知れないことに関しては、ラッキーだと思っています。これからの社会を担う若い方々には、ぜひ自分の知的好奇心を大切にしてほしいと願っています。特に無機材料には、わかっていないことが未だにたくさんあります。私も謎の解明や未知の発見に向け、今後も学生たちとともに研究を楽しんでいこうと思っています。
科学技術創成研究院 化学生命科学研究所 上田宏 教授
専門分野は機能性タンパク質(主として抗体)です。端的に言うと、タンパク質を人間にとって使いやすいように、人工的に作り替える研究です。体内にウイルスなどの病原体が侵入すると、その異物を抗原として認識し、これら標的を抑制・排除するための抗体が作られます。この人体の免疫機能のことを、抗原抗体反応といいます。抗体は認識する分子の特異性が非常に高く、医薬品としても利用されています。このような作用機序を用いて、機能性タンパク質の研究開発を行っています。
近年では、抗原抗体反応を利用した抗原の濃度測定法(免疫測定法)も開発されています。さまざまな種類の病原体を検出できることから、検査・診断における優れた測定法として重要性が増しています。しかし、より簡便、迅速、高感度で測定できることが求められています。それに対し、私の研究室では、新規蛍光免疫測定素子「Q-body」を開発しました。Q-bodyは、免疫測定に用いる抗体分子に、蛍光色素を結合させたものです。通常、この蛍光色素は消光(Quench)しており、抗原と結合することで初めて蛍光を発することから、高い感度で測定できることが最大の特徴です。Q-bodyを用いることで、インフルエンザウイルスについても微量で検出が可能となりました。Q-bodyを抗原が解けている溶液に混ぜるだけで検出が可能ですので、操作が簡便で、迅速、低コストという点も特徴です。
加えて、私達の研究室では、准教授の北口先生と一緒に細胞内で抗原が結合すると光るバイオセンサー「Flashbody」なども開発しています。これは、抗体に蛍光タンパク質を結合させたもので、細胞内にウイルスなどの抗原が取り込まれると、蛍光顕微鏡を使って観察できるのが長所です。


Q-body:●抗原結合により蛍光が強まる抗体 ●サンプルと混合するだけで抗原を高感度に蛍光検出できる。
R. Abe, et al. J. Am. Chem. Soc. 133, 17386-17394 (2011). [10.1021/ja205925j]![]()
Q-bodyもFlashbodyも原理は多少異なりますが、標的とする抗原への結合能力が高いのが特徴です。例えば、今後Q-bodyを使って新型コロナウイルス(SARS-CoV-2)を高精度で検出するには、最適な抗体を見つけ出すことがポイントになります。現在、候補となる抗体が挙がってきていますので、その性能を調べているところです。また、感度を上げ、コストを下げることが課題となります。1つの抗体では、抗原との結合能力に限界がありますが、複数個の抗体を連結させることで結合能力を高め、感度を上げていく計画です。
米国では、ウイルスがつくと蛍光を発するマスクが開発されているそうですが、私もこのようなものを作りたいと思っています。実際にウイルスを目で見るということが実現すると有用だと思います。


Anti-Influenza H1N1 Q body:サンプルと混合するだけで nM レベルの HA 抗原を蛍光検出できた。
H.J. Jeong , J. Dong and H. Ueda "Single step detection of influenza virushemagglutinin using bacterially produced Quenchbodies" Sensors 19, 52 (2019). [1424-8220/19/1/52]![]()
Q-bodyやFlashbodyの実用化に向けては、パートナー企業を広く募集しています。できるだけ早く実用化を目指します。COVID-19はなかなか終息がみえず世界中での感染拡大が懸念されており、診断・治療ともに急を要する事態です。このような中、Q-bodyのような簡便で、安価な免疫測定系開発を通じてwith/afterコロナ時代の生活の安全安心確保に少しでも役立ちたいと考えています。
上田宏教授からのメッセージ

上田 宏
科学技術創成研究院
化学生命科学研究所 教授
上田宏教授からのメッセージ
私自身は化学工学が専門ですが、私が学生時代、バイオテクノロジーブームが起こり、所属していた研究室の教授が「タンパク質工学」に注力し始めたことから、私も傾倒するようになりました。その中で、私は、抗原抗体反応に興味を抱き、ヒト型抗体の作製を学ぶため、ケンブリッジ大学のラボに留学しました。とはいえ、将来、医薬品を開発して社会に貢献しようと意気込んだわけではなく、単なる研究の面白さからでした。今回、COVID-19が感染拡大する中、注力している「Q-body」に関しても、抗原が結合すると蛍光を発するという性質は偶然見つけた現象であり、決して狙ったものではありません。これらの経験から私が若い方々に伝えたいことは自分が面白いと思うことを大切にしてほしいということです。社会に役立つ研究かどうかは誰にもわかりません。
科学技術創成研究院 未来産業技術研究所 飯野裕明 准教授
私の専門は有機材料を使って半導体デバイスを作る「有機エレクトロニクス」です。従来の無機材料を使った半導体デバイスとは異なり、室温で印刷技術を使って製造できるので、低エネルギー、低コストなのが特徴です。フレキシブルで軽量なプラスチック基板に作製することで、身体への装着が可能なウェアラブルデバイスとしての応用などが期待されています。また、IoT向けに、使い捨て可能なセンサーデバイスとしても有望視されています。
その中で、私の研究の独自性は、液晶の有機材料を使っている点です。液晶とは、固体と液体の中間の性質をもつ物質で、液晶ディスプレーはその性質を利用した一つの応用です。通常、有機材料できれいな結晶の薄膜を作るのは非常に大変なのですが、液晶の有機材料の場合、溶液に溶かし基板に塗って乾かすだけで、簡単にきれいな結晶の薄膜を作ることができます。その理由は、液晶の有機材料の分子同士が自己組織的に規則正しく並ぶためです。結晶がきれいで密な方が、電子がその中を高速に移動できるため、半導体デバイスとしての性能が向上します。現在は、この有機材料を使った薄膜トランジスタと近赤外線フォトダイオードの研究開発に注力しています。そして、この2つを集積させることで、近赤外線イメージセンサーの開発を目指しています。イメージセンサーとは、光を電気信号に変換する撮像素子のことです。私が扱っている有機材料は、近赤外線を吸収しやすい性質をもっています。これまで私は、医療応用は考えておらず、有機薄膜太陽電池への応用を想定していました。しかし、近赤外線は生体の透過性が高いことから、身体に近赤外線イメージセンサーを貼り付けておき、外から近赤外線を照射することで、体内を撮影することができます。今回、新型コロナウイルスに感染すると血栓ができやすくなると聞き、近赤外線イメージセンサーを使えば、体内の血管をイメージングして、血栓の早期発見に貢献できるのではないかと考え、検討を始めたところです。


左図上図:自己組織化有機半導体材料(Ph-BTBT-10)の化学構造とその分子の凝集構造、薄膜トランジスタの構造
右図下図:フレキシブル基板上に作製した薄膜トランジスタ

左図:自己組織化有機半導体材料(8H2Pc)の化学構造とフォトダイオードの構造
右図:フレキシブル基板上に作製したフォトダイオード

自己組織化有機半導体材料(8H2Pc)の化学構造とフォトダイオードの構造

フレキシブル基板上に作製したフォトダイオード
私自身は医療分野に関する知識がないため、今後、ECMOの血液ポンプの研究をされている工学院の土方亘先生や科学技術創成研究院の進士忠彦先生などと共同で、近赤外線イメージセンサーの医療応用を進めていく計画です。COVID-19のような感染症の場合、人体に直接触れる半導体デバイスには、安価で使い捨て可能なものが求められます。その点で、有機材料を使った半導体デバイスの有用性は高いと感じています。しかし、実用化に向けてはさらなる生産性や安定性の向上が不可欠です。
近赤外線イメージセンサーの医療応用に向けては検討を始めたばかりで、実際に役立つ性能を発揮できるかなど未知数ですが、少しでも貢献できるよう尽力していく所存です。
飯野裕明准教授からのメッセージ

飯野 裕明
科学技術創成研究院 未来産業技
術研究所 准教授
飯野裕明准教授からのメッセージ
私の専門分野は有機エレクトロニクスであり、医療分野にはこれまで無縁でしたので、医療分野の方々との共同研究は予想外の展開です。また、私が研究開発中の近赤外線イメージセンサーが、実際に医療の現場で有用なものなのかどうかはこれから検証していくことですので、どうなるかわかりませんが、私にとっては新たな挑戦です。このような経験を通して、私が若い方々に伝えたいことは、その時々、自分が興味があることに全力投球してほしいということです。その積み重ねが、思いがけない展開を生む場合があります。実際、私の研究室でも、実験中に予想もしていなかったような新たな現象が見つかることがあることから、学生たちには、常日頃から、予想外の展開を大切にしてほしいと伝えています。
工学院 土方亘 准教授
COVID-19によりウイルス性肺炎を発症して重症化すると、呼吸困難に陥ります。通常は人工呼吸器が使われますが、自分の肺を使って呼吸することすら困難な患者さんに対しては、最後の砦として、ECMO(体外式膜型人工肺)が導入されます。ECMOは、血液ポンプで患者さんの血液を人工肺に送り、血液中の二酸化炭素(CO2)を除き、酸素(O2)を供給した血液を体内に戻すというしくみです。
私はこれまで、このECMOの血液ポンプの部分の研究開発を進めてきました。血液ポンプは、インペラと呼ばれる羽根車を回転させて血液を送り出しています。通常の羽根車であれば、軸受けが回転によって摩耗しないように、潤滑油をさすのですが、血液ポンプの場合、インペラは血液に完全に浸っているため、潤滑油をさすことができず、耐久性が低いという課題を抱えています。加えて、インペラによって赤血球がすりつぶされてダメージを受けたり、血栓ができやすいという課題もあります。それに対し、私はもともと本学未来産業技術研究所の進士教授のもとで電磁力を使ってインペラを浮上させて回転させることで、これらの課題を解決する血液ポンプを開発してきました。現在、開発した血液ポンプは臨床応用に向けて各種試験を実施中です。

磁気浮上血液ポンプ
COVID-19の患者さんは、血栓症を発症しやすいという研究発表がされています。血栓ができると、脳梗塞や心筋梗塞になるリスクが高まります。そのため、ECMOについては、従来にも増して、血栓ができにくい血液ポンプの開発が強く求められており、血栓ができにくい材料や形状のインペラの研究開発が世界各国で進められています。私は、インペラの表面に血液が付着することで血栓ができやすくなることに着目し、電磁力を使って浮上させたインペラに、新たに高周波の振動を与えることで、インペラ表面に血栓が付着しにくくするという方法を考えました。実験をしてみたところ、インペラが振動していない場合に比べて、振動している場合の方が、血栓の付着が劇的に減っていることが確認されました。


ECMO用磁気浮上血液ポンプ
現在、このインペラを搭載した血液ポンプの実用化に向け、東京医科歯科大学、旭川医科大学と共同で研究開発を進めているところです。この技術の長所は、プログラムを変えるだけで対応できるので、既存のECMOへの適用が可能なことです。急を要する状況の中、1日も早い実用化に向け、実証実験を進めて参ります。また、COVID-19に限らず、今後も新たなウイルスの出現が考えられます。工学の立場から医療分野への貢献を果たしていきます。
土方亘准教授からのメッセージ

土方 亘
工学院 機械系 准教授
土方亘准教授からのメッセージ
自分自身は機械工学が専門であり、医者ではありませんが、工学の立場からでも人々の命を救う仕事ができるということに、大きな手応えとやりがいを感じています。若い方々にも、工学の立場からでも多くの人の命を救うことができるということをぜひ知っていただきたいですね。特に近年は、医工連携が進んでおり、医学者と工学者の連携が、医学の発展と革新においてますます重要になってきています。また、先進国を中心に少子高齢化が進む中、医療用ロボットや介護ロボット、医療デバイスなどの研究開発も加速しています。私も今後も工学の立場から医工連携を推し進め、豊かな社会の実現を目指していきます。
情報理工学院 関嶋政和 准教授
私の専門分野は、機械学習やスパコンによる大規模シミュレーションなど情報科学技術を用いた「IT創薬」です。現在、製薬会社では1つの新薬を上市するのに約3,000億円、10年以上を要しています。そこで、近年、新薬の候補化合物を探索するためのバーチャルスクリーニングにITを使う動きが盛んです。
薬となる化合物と、病気に関係するタンパク質とは、鍵と鍵穴の関係にあることから、私の研究室では、東工大のスパコン「TSUBAME」を用いて、「ドッキングシミュレーション」を実行することで候補化合物の絞り込みを行っています。これは、タンパク質の鍵穴と候補化合物の鍵がうまく結合するかどうかをシミュレーションによって確認するというものです。それにより、(COVID-19ではない)ある病気について、約500万個の候補化合物から、約180個への絞り込みと生化学実験での検証で4つのヒット化合物の獲得に成功しています。
しかし、絞り込んだ候補化合物の中には、生化学実験の結果、うまく結合しないものも多く含まれていることから、新たにタンパク質のアミノ酸と候補化合物との相互作用を機械学習など人工知能(AI)を用いて評価するツール「SIEVE-Score」などを国立研究開発法人日本医療研究開発機構(三島良直 理事長) 創薬等先端技術支援基盤プラットフォーム(BINDS)と連携して開発し、バーチャルスクリーニングの精度の向上を図っています。
2020年1月上旬という早い段階で、中国の研究グループが、新型コロナウイルス(SARS-CoV-2)のゲノム情報を公開しました。この情報から、SARS-CoV-2とSARSウイルス(SARS-CoV)のゲノム配列が似ていることを知り、SARSに関する研究がCOVID-19に活かせるだろうと直感しました。
特に、ウイルスの増殖に必須であるメインプロテアーゼという酵素の働きを阻害する候補化合物が様々なウイルスで知られています。それらの候補化合物がSARS-CoV-2のメインプロテアーゼにどのように結合しているかを、TSUBAMEを使い、分子の動きを追跡する「分子動力学シミュレーション」により調べました。その結果、「ファーマコフォア」と呼ばれる、タンパク質と候補化合物との相互作用を表す立体構造のモデリングに成功しました。今後はこの成果を踏まえつつ、さらに、SIEVE-Scoreを使うことで、既存薬の中から、SARS-CoV-2の増殖を阻害する候補化合物の絞り込みを行っていく計画です。


SARS-CoV-2のメインプロテアーゼと医薬品候補であるα-ケトアミド阻害剤に関して、本研究でモデリングしたファーマコフォアへの適合を検証。α-ケトアミドはペプチド様の化合物でウイルスのメインプロテアーゼ活性を阻害することが知られている。SARS-CoV-2のメインプロテアーゼとα-ケトアミドが相互作用することが推測されており、この図のようにファーマコフォアモデルで相互作用する化合物を捜すことで、SARS-CoV-2の治療薬候補を見出すことが可能と考えられる。
Ryosuke Yoshino, Nobuaki Yasuo and Masakazu Sekijima
"Identification of key interactions between SARS–CoV–2 main
protease and inhibitor drug candidates"
Scientific Reports vol 10, Article number: 12493 (2020)
今回のCOVID-19のパンデミックから私が得た教訓は、今後もいつ新たなパンデミックが発生するか分からない中、それに対応するためのプラットフォームを早急に整備する必要があるということです。プラットフォーム上で、各種ウイルスのゲノム配列や立体構造、その働きを阻害しそうな候補化合物を一元管理し、シミュレーションツールや機械学習を使って迅速に解析することで、候補化合物の絞り込みや創薬につなげていきたいと考えています。
関嶋政和准教授からのメッセージ

関嶋 政和
情報理工学院 情報工学系 准教授
関嶋政和准教授からのメッセージ
私は情報工学が専門で、これまで、寄生原虫による感染症などを対象に、コンピューター・シミュレーションによる治療薬の探索などを行ってきました。近年は機械学習など人工知能も駆使することで、精度の向上を図っています。これまでは、シャーガス病やアフリカ睡眠病など、発展途上国で蔓延しているため治療薬が開発されていない感染症が対象でしたが、私の研究は幸運にもCOVID-19の研究に役立つことが出来ました。一方で、我々の社会が抱えているリスクは、洪水や地震など他にもたくさんあります。このようなリスクに対しては、私の研究は無力です。ですから、若い方々に伝えたいことは、その時々に応じて自分にできる社会貢献をしてほしいということです。自分自身の研究に真摯に向き合っていれば、それが役立つ日がいつか訪れると思います。
スペシャルトピックスでは本学の教育研究の取組や人物、ニュース、イベントなど旬な話題を定期的な読み物としてピックアップしています。SPECIAL TOPICS GALLERY から過去のすべての記事をご覧いただけます。
2020年8月掲載